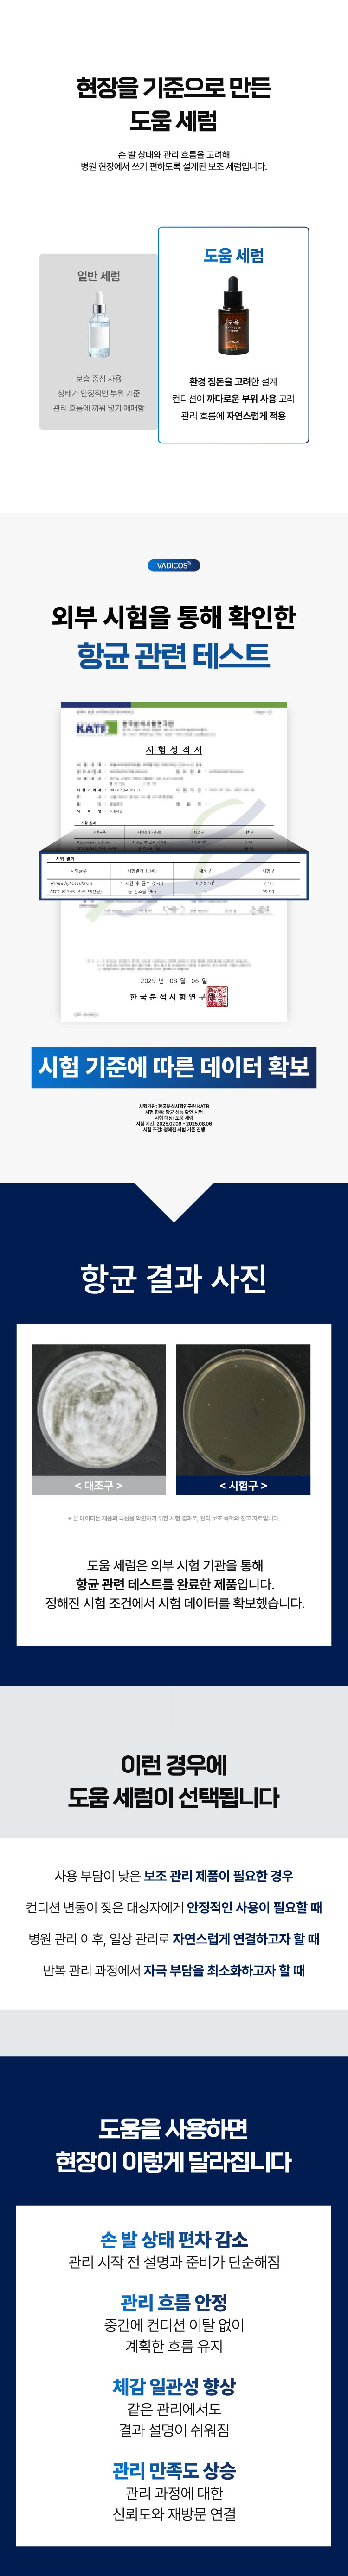
c57c6-69898d3fbfb83-c25df5127b9c375d2b1fabb2491d1bbf01a9cb46.jpg

등록된 상품이 없습니다.

| 품명 | 상품페이지 참고 |
|---|---|
| 모델명 | 상품페이지 참고 |
| 법에 의한 인증·허가 등을 받았음을 확인할 수 있는 경우 그에 대한 사항 | 상품페이지 참고 |
| 제조국 또는 원산지 | 상품페이지 참고 |
| 제조자 | 상품페이지 참고 |
| A/S 책임자와 전화번호 또는 소비자상담 관련 전화번호 | 상품페이지 참고 |

교환 및 반품 주소
- [04071] 서울특별시 마포구 성지길 22 (합정동) 2층 201호
교환 및 반품이 가능한 경우
- 계약내용에 관한 서면을 받은 날부터 7일. 단, 그 서면을 받은 때보다 재화등의 공급이 늦게 이루어진 경우에는 재화등을 공급받거나 재화등의 공급이 시작된 날부터 7일 이내
- 공급받으신 상품 및 용역의 내용이 표시.광고 내용과 다르거나 계약내용과 다르게 이행된 때에는 당해 재화 등을 공급받은 날 부터 3월이내, 그사실을 알게 된 날 또는 알 수 있었던 날부터 30일이내
교환 및 반품이 불가능한 경우
- 이용자에게 책임 있는 사유로 재화 등이 멸실 또는 훼손된 경우(다만, 재화 등의 내용을 확인하기 위하여 포장 등을 훼손한 경우에는 청약철회를 할 수 있습니다)
- 이용자의 사용 또는 일부 소비에 의하여 재화 등의 가치가 현저히 감소한 경우
- 시간의 경과에 의하여 재판매가 곤란할 정도로 재화등의 가치가 현저히 감소한 경우
- 복제가 가능한 재화등의 포장을 훼손한 경우
- 개별 주문 생산되는 재화 등 청약철회시 판매자에게 회복할 수 없는 피해가 예상되어 소비자의 사전 동의를 얻은 경우
- 디지털 콘텐츠의 제공이 개시된 경우, (다만, 가분적 용역 또는 가분적 디지털콘텐츠로 구성된 계약의 경우 제공이 개시되지 아니한 부분은 청약철회를 할 수 있습니다.)
※ 고객님의 마음이 바뀌어 교환, 반품을 하실 경우 상품반송 비용은 고객님께서 부담하셔야 합니다.
(색상 교환, 사이즈 교환 등 포함)